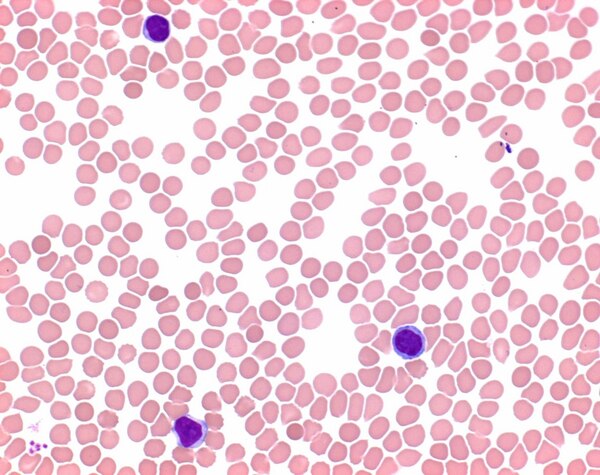
1014242500.jpg

* Imagem meramente ilustrativa
SOL. DE EOSINA-AZUL DE METILENO SEG. MAY-GRUNWALD (P/ MICROSCOPIA ) MERCK - FR. 2,5L
Modelo: 1014242500
R$ 260,52
ou até 3x de R$ 86,84 sem juros
Economize 5% no PIX: R$ 247,49
ou 3,5% no boleto: R$ 251,40
Calcular Frete
Descrição
Informações fisico-químicas:
Ponto de ebulição: 65 °C (1013 hPa)
Densidade: 0.79 g/cm3 (20 °C)
Limite de explosão: 5.5 - 44 %(V) Metanol
Ponto de fulgor: 12 °C
Temperatura de ignição: 420 °C
Pressão de vapor: 128 hPa (20 °C)
Especificações:
Suitability for microscopy (Blood smear): passes test
Erythrocytes: pink to brownish
Nuclei: violet
Eosinophilic granules: red-brown
Neutrophilic granules: light violet
Lymphocyte cytoplasm: blue
